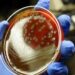
Щорічно у світі фіксують 30 мільйонів випадків сепсису, а близько 6 мільйонів людей помирають через цю недугу. Фото: botkin.pro

У тихому й мальовничому селі Ліщинка Кагарлицького району на Київщині, подалі від міської метушні розкинулася ферма-агросадиба «Ясна». Нею опікується молода підприємиця Дана Сєрьогіна. Вона ж є головною сироваркою на власній сироварні, розташованій у столиці. Нещодавно сир «Повня» (кротен у попелі), зварений у сироварні, отримав гран-прі на національному конкурсі сирів.
Прагнули створити «гавань спокою»
Ферму заснували батьки Дани у листопаді 2022 року. Тоді під час ворожих обстрілів їхній будинок зазнав пошкоджень. І на тлі тих подій знайомі запропонували створити ферму у тихому селі – як «гавань спокою» на фоні руйнувань. Дана у той час навчалася в Іспанії, здобувала знання у царині готельно-ресторанного бізнесу. До роботи на фермі доєдналася у травні 2023 року. «Після стажування у Гонконзі я усвідомила, що ця справа мені не до душі, – розповідає Дана. – Тому повернулася додому і з головою занурилася у роботу на фермі, а згодом стала на чолі родинного бізнесу. Я дуже вдячна батькам за підтримку, що допомогли мені знайти заняття, яке подобається, знайти свій шлях у житті».

Крім облаштування ферми, Дана почала вчитися варити різні види сирів. «Так сталося, що ми залишилися без сировара. І тоді я розпочала свій шлях у сироварінні, – продовжує дівчина. – Спочатку навчалася по відео з Ютубу. Згодом вдалося поїхати в Італію у сирну поїздку із засновницею школи сироваріння Іриною Дем’янюк. Таким чином стала дотичною до спільноти сироварів, навчалася на різних курсах. Крім того, постійно практикувала, адже мала власних кіз та молоко для переробки. Так внаслідок власної практики, набутих знань навчалася варити різні види сиру».
Нині на фермі живуть 30 кіз, з яких 18 дійні. Усі – англо-нубійської породи. «Молоко цих кіз має особливий смак пломбіру і без специфічного запаху, – пояснює Дана Сєрьогіна. – Крім власного молока, беремо на переробку молоко ще з двох ферм, теж від кіз англо-нубійської породи. Ми були на тамтешніх фермах, бачили, як там доглядають за козами, тому впевнені у сировині».
Візитівка сироварні – сир «Повня» (кротен у попелі)
Сироварня розташована у Києві. На ній працюють Дана з помічницею. Працює сироварня два дні на тиждень, за цей час вдається переробити 350 літрів молока. «Спеціалізуємося ми на м’яких сирах та сирах з білою пліснявою, – розповідає про своє дітище Дана. – Цього року активно розвиваємо напрямок витриманих сирів, щоб мати запас на зиму. Найбільшим попитом користуються м’які сири – бринза, адигейський та рікота – і сири з білою пліснявою – брі й наша візитівка – «Повня» (кротен у попелі). Це кислоферментний сир, покритий білою пліснявою, з вершково-кремовою текстурою всередині. Він здобув гран-прі на національному конкурсі сирів як найкращий сир 2025 року. «Серед 81 сиру міжнародні судді обрали саме нашу «Повню», – пишається Дана. – Це величезне визнання для маленької та ще зовсім молодої сироварні. Ми вже два роки з любов’ю створюємо цей сир, постійно вдосконалюючи його. І ця нагорода – доказ, що праця не була марною. Якби хтось сказав мені про це два роки тому, коли я, 18-річна, тільки починала свій шлях, варила першу партію кротену з десяти літрів молока і думала, що зіпсувала її, я б ніколи не повірила. А виявилося – це був початок великої історії».

Агротуризм
Ферма «Ясна» відкрита для відвідувачів, тут для туристів організовують екскурсії, на яких відвідувачі можуть познайомитися з козами, погуляти мальовничим селом, а також скуштувати різні види сирів.
«Ми долучаємося до різних благодійних ініціатив на підтримку військових. Нещодавно, до прикладу, брали участь у заході «Обличчя незалежності». А при замовленні сирів передбачаємо пільги для військових», – каже підприємиця.
У молодої, активної і енергійної Дани багато задумів та планів. «Це – удосконалення виробництва, встановлення максимально усіх стандартів якості, розширення виробництва сирів з білою пліснявою, плануємо виходити на торговельні мережі», – ділиться Дана. А ще дівчина мріє відкрити власний магазин у столиці, де українці зможуть придбати сир та інші натуральні продукти з ферми.